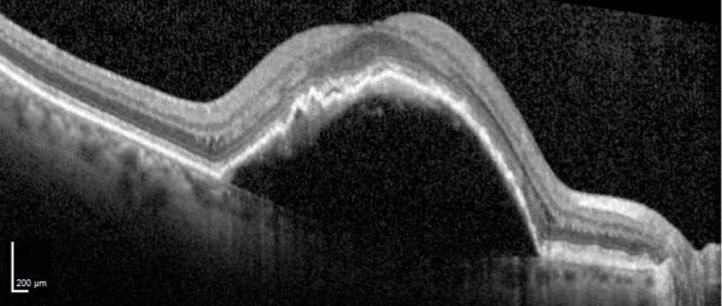

Title:
Resolution of anti-VEGF resistant serous pigment epithelium detachment with dexamethasone implant
Authors:
C. Ellis Wisely, Ananth Sastry, Sharon Fekrat
Pigment epithelium detachment (PED) is often a manifestation of age-related macular degeneration (AMD).1 PEDs are formed when the retinal pigment epithelium (RPE) separates from Bruch membrane due to the presence of material in the sub-RPE space. PEDs may occur when there is increased Bruch membrane resistance to water flow as a result of excess lipid deposition.2 Pepple and Mruthyunjaya (2011) reviewed the pathogenesis and treatment of the major subtypes of PEDs: drusenoid, serous, fibrovascular, and hemorrhagic.3 Serous PEDs are commonly seen in neovascular AMD and are typically treated with anti-vascular endothelial growth factor (VEGF) therapy and in some recalcitrant cases, with photodynamic therapy (PDT). Moreover, some reports describe differences in efficacy of anti-VEGF agents for serous PEDs, with eyes responding more favorably to aflibercept.4
Intravitreal corticosteroid treatment, though less commonly employed, has also been described as an effective therapeutic option for serous PEDs associated with neovascular AMD.5 Pasyechnikova and coworkers (2012) treated 19 eyes with intravitreal triamcinolone acetonide monotherapy, with reattachment of PEDs in 37% of eyes, and decreased PED size in each of the other treated cases.5
A 75-year-old woman with longstanding neovascular AMD responsive to aflibercept in her left eye developed a new serous pigment epithelium detachment in the right eye
Corrected ETDRS visual acuity in the right eye declined from 20/32 to 20/64-2. Intravitreal therapy with aflibercept was instituted monthly for three consecutive months. After three injections, corrected ETDRS visual acuity remained 20/64, and the PED had increased significantly in size (Figure A). Given the recalcitrant nature and height of the PED, combination therapy with an intravitreal corticosteroid, specifically an intravitreal 0.7 mg dexamethasone implant (OZURDEX), along with repeat intravitreal aflibercept was administered. One month later, the PED had resolved (Figure B). Intraocular pressure was 19 mmHg. Visual acuity remained 20/64.

Figure: Heidelberg Spectralis spectral domain optical coherence tomography image of the right eye. All scans are horizontal foveal scans. A) One month prior to development of pigment epithelial detachment (PED), drusen are apparent. B) Development of large PED, maximum vertical dimension 289 μm. C) After three monthly intravitreal aflibercept injections., the PED was significantly increased with a maximum vertical PED dimension 630 μm. D) One month after intravitreal 0.7 mg dexamethasone implant (OZURDEX) combined with repeat intravitreal aflibercept injection, the PED resolved. Visual acuity remained 20/64.
References:
- 1) Gass JD. Drusen and disciform macular detachment and degeneration. Trans Am Ophthalmol Soc. 1972;70:409-36.
- 2) Holz, F., Pauleikhoff, D., Klein, R., Bird, A. Pathogenesis of lesions in age-related macular disease. Am J Ophthalmol. 2004;137:504-510.
- 3) Pepple, K., Mruthyunjaya, P. Retinal pigment epithelial detachments in age-related macular degeneration: classification and therapeutic options. Semin Ophthalmol. 2011; 26:198-208.
- 4) Patel, K., Chow, C., Rathod, R., Mieler, W., Lim, J., Ulanski, L., Leiderman, Y., Arun, V., Chau, F. Rapid response of retinal pigment epithelial detachments to intravitreal aflibercept in neovascular age-related macular degeneration refractory to bevacizumab and ranibizumab. Eye. 2013; 27:663-668.
- 5) Pasyechnikova, N., Naumenko, V., Korol, A., Zadorozhnyy, O., Kustrin, T., Nasinnyk, I. Serous pigment epithelium detachment associated with age-related macular degeneration: a possible treatment approach. Med Hyopthesis Discov Innov Ophthalmol. 2012: 1:72-75.